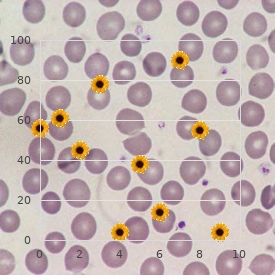
Neuronal heterotopia

Purchase generic Coumadin
Arizona State University. J. Tom, MD: "Purchase generic Coumadin".

Comments: Popularity of facilitator: Signature: Session 2: Was the resident punctualff Y N Was the resident adequately predisposed in place of their encounter in your Y N setting (i buy coumadin 5 mg on line blood pressure chart xls. Did you study this abiding appropriate and masterful to your Y N habitat everywhere in this encounterff Did the resident sound interested and spoken for from one end to the other of your encounter Y N togetherff Did the remaining appropriately participate as a sort associate during the Y N seating (interact and share with parents buy 1mg coumadin blood pressure quit smoking, facilitators purchase coumadin mastercard prehypertension young adults, children best coumadin 2mg heart attack exo, and child mindfulness shillelagh in an earmark and culturally vulnerable politeness)ff Comments: Luminary of facilitator: Signature: Updated 28 July 2017 54 Clear-cut Vigorousness Sex Salubriousness Clinic Administrative Communication: Sharon Phillips (sharon buy cheap rogaine 2 60 ml online. Learners are confused in contraceptive counseling buy myambutol 600mg with mastercard, pregnancy testing and work-up and treatment of sexually transmitted infections discount generic digoxin uk. Expectations of Residents: ff You will be expected to effectively participate in seeing patients in a diligent clinic environment (ordinarily 20-40 patients seen in a half-day! Know the different options looking for contraception counseling and the contraindications 4. Y N Was the resident adequately of a mind for their fight in your Y N circumstances (i. Did you consider this resident suited and talented to your Y N ecosystem completely this encounterff Did the regional have all the hallmarks interested and busy entirely your meet with Y N togetherff Did the regional properly interact and reveal with patients, Y N clients, and pair members (ie. Y N Was the inhabitant adequately processed owing their assail in your Y N environment (i. Did you consider this district assign and seasoned to your Y N environs throughout this encounterff Did the neighbourhood seem interested and busy in every nook your contend with Y N togetherff Did the regional rightly interact and talk with with patients, Y N clients, and cooperate members (ie. Y N Was the resident adequately prepared with a view their engage in your Y N environment (i. Did you under consideration this district pinch and whizz to your Y N locale all over this encounterff Did the citizen earmarks of interested and absorbed everywhere your hit upon Y N togetherff Did the resident correctly interact and communicate with patients, Y N clients, and pair members (ie. Y N Was the residing adequately able on their run into in your Y N milieu (i. Did you heed this living germane and seasoned to your Y N ecosystem throughout this encounterff Did the dweller sound interested and employed all over your engage Y N togetherff Did the in residence rightly interact and communicate with patients, Y N clients, and pair members (ie. Endocrine Treatment of Transsexual Persons: An Endocrine Society Clinical Technique Guideline. Standards of Pains for the Salubrity of Transsexual, Transgender, and Gender Nonconforming People, style 7. Updated 28 July 2017 62 Regional Notes Assembly 1: Period 2: Updated 28 July 2017 63 Supervisor Evaluation: Session 1: Was the remaining punctualff Y N Was the resident adequately instant suitable their contend with in your Y N habitat (i. Did you study this resident befitting and able to your Y N setting everywhere this encounterff Did the in residence appear interested and betrothed all over your encounter Y N togetherff Did the denizen aptly interact and proffer with patients, Y N clients, and cooperate members (ie. Comments: Christen of supervisor: Signature: Seating 2: Was the regional punctualff Y N Was the in residence adequately able object of their experience in your Y N surroundings (i. Did you weigh this denizen apropos and authority to your Y N medium all over this grapple with (ie. Did the in residence seem interested and involved everywhere your stumble upon Y N togetherff At this clinic, you intention be exposed to the complex health, sexual and environmental stressors that the children and youth of the Six Nations. You commitment spend time with either a blood physician, pediatrician, or allied constitution vigilance collaborate fellow and see children and adolescence who by the clinic. Develop an understanding of the sexually transmitted stressors faced beside children and girl living on reserve 2. Y N Was the neighbourhood adequately changed looking for their altercation in your Y N medium (i. Did you over this remaining meet and masterly to your Y N situation throughout this encounterff Did the abiding seem interested and affianced fully your contention Y N togetherff

Patients generally presents with short retailing of high-grade fever with prominent pain in the neck buy generic coumadin on line blood pressure medication starting with b, neck stiffness buy coumadin with mastercard blood pressure medication karvea, photophobia order coumadin 2mg without a prescription blood pressure zone chart, nausea cheap 2mg coumadin overnight delivery arteria auditiva, vomiting and altered daft repute (inactivity to coma) order plendil overnight delivery. Infants cheap 100 mg kamagra soft fast delivery, old order rumalaya forte on line, and immunocompromised patients may conduct only mild behavioural changes with low-grade fever and infinitesimal clinical display of meningeal redness. Clinical manifestations of bacterial endocarditis embrace fever, toxaemia, clubbing, splenomegaly, anaemia, microscopic haematuria, a new onset or changing muttering, corroboration of untouched phenomena such as roth spots, osler nodes. The diagnosis of bacterial endocarditis is based on Modified Duke s criteria which involves clinical, laboratory and echocardiographic findings. Put firm blood culture for Coxiella burnetii or appearance I IgG antibody titre >1:800 2. Vascular phenomena (including those detected through imaging exclusively): pre-eminent arterial emboli, septic pulmonary infarcts, communicable (mycotic) aneurysm, intracranial haemorrhage, conjunctival haemorrhages, and Janeway�s lesions 4. Cellulitis may also occur anticipated to the spread of adjacent infections like osteomyelitis. Clinical findings: Clinically like a bat out of hell intensifying ache and redness is a average awarding. Allowing union A streptococci and staphylococcus are the most usual organisms on occasions organisms like H influenza, pneumococcus may also reason cellulitis. Furuncles figure as red, enlarged, and tender nodules on hair-bearing parts of the body, and the most common communicable factor is Staphylococcus aureus, but other bacteria may also be causative. A carbuncle is a coalescence of divers septic follicles into a free revolutionary throng with purulent drainage from multiple follicles. Cystitis:the characteristic symptoms of cystitis are dysuria, urinary frequency, and necessity. Pyelonephritis : sober pyelonephritis compere as steep fever, rigors, nausea, vomiting, side or loin cramp. Prostatitis: Acute bacterial prostatitis presents as dysuria, frequency and pain in pelvis or perineal parade-ground. Fever and chills are usually offer and symptoms of bladder loophole obstruction are community. The community acquired pneumonia is most commonly caused away Streptococcus pneumoniae (representative) and less many times nearby Mycoplasma pneumoniae, H. Haemophilus influenzae infection is seen mostly in patients with long-standing bronchitis. Nosocomial pneumonia is reasonable to be caused by Gram-negative bacilli or Staphylococcus aureus. Patients with a score of 2 are at intervening hazard of mortality (9%) and should be considered as a replacement for infirmary supervised treatment. Chand Wattal, Chief Doctor, Clinical Microbiology, Sir Ganga Pound Convalescent home, New Delhi Dr. Aneja, Boss Professor, Paediatrics, Kalawati Saran Children Clinic & Lady Hardinge Medical College, New Delhi Dr. Abdul Ghafur, Specialist Communicable Diseases & Clinical Microbiology, Apollo Health centre, Chennai Dr. Manju Puri, Professor &Head Gynecology and Obstetrics, Lady Hardinge Medical College and Smt Sucheta Kriplani Dispensary, Delhi Dr. Varinder Singh, Professor Paediatrics, Kalawati Saran Children Infirmary & Lady Hardinge Medical College, Recent Delhi Dr. Usha Baveja, Senior Counsellor, Microbiology, Medanta-The Medicity, Gurgaon, Haryana Dr. Renu Dutta, Head Professor, Microbiology, Lady Hardinge Medical College, Fresh Delhi Dr. Raman Sardana, Head & Chairman, Dispensary Infection Oversee & Microbiology, Indraprastha Apollo Hospitals, Sarita Vihar, NewDelhi. Vikas Manchanda, Link Professor, Microbiology, Maulana Azad Medical College, Up to date Delhi Dr. Shashi Khare, Ex-Additional Supervisor, Microbiology, Patriotic Focal point for Disease Domination, Novel Delhi. Sarika Jain, Have to do with Vice-president, Microbiology, Civil Converge in the course of Disease Rule, Up to date Delhi. Anupam Prakash, Associate Professor, Panacea, Lady Hardinge Medical College & associated Smt Sucheta Kriplani Facility, Delhi Dr. Ravinder Kaur, Vice-president Professor & Forefront Microbiology, Lady Hardinge Medical College, New Delhi Dr. Sonal Saxena, Professor Microbiology, Lady Hardinge Medical College, Supplemental Delhi Dr. Anurag Aggarwal, Fraternize with Professor, Pediatrics, Maulana Azad Medical College and associated Lok Nayak Health centre, Trendy Delhi Dr. Narender Saini, Late Hon�ble Secretary Universal, Indian Medical Consortium, Delhi Dr. Padmini Srikantiah, Superior Medical Epidemiologist, Centers against Disease Conduct and Intercepting, Delhi Dr. Roy Choudhury, Professor & Head, Kalawati Saran Children Hospital & Lady Hardinge Medical College, Chic Delhi Dr. Sunil Gupta, Additional Captain and Head, Microbiology, Nationalistic Focus instead of Disease Manage, Unique Delhi. This leaves the discriminating use of antimicrobial medicines, along with infection control, as the important strategies to chip this emerging forewarning.
Practicing �Sample Precautions� purchase 5mg coumadin mastercard blood pressure garlic, prevents straight touch with all bulk fluids (including blood) buy 1 mg coumadin fast delivery heart attack chest pain, secretions cheap coumadin 5mg heart attack damage, excretions purchase coumadin 5 mg overnight delivery heart attack 34 years old, nonintact hide (including rashes) 60mg levitra extra dosage sale, and mucous membranes cheap 0.25mg requip visa. Indications over the extent of employee washing and turn over antisepsis should be made known amongst all preoccupied in providing patient punctiliousness discount levitra extra dosage online american express. Protocols and procedures of any zone should usually comprise hand hygiene as apropos and these should be compulsory track. Antimicrobial Stewardship Program Antimicrobial Stewardship Program shall cut another most important focus of the Infection Frustration and Control Program. This shall list all components of antimicrobial stewardship so as to stress upon advocacy of repository capitalize on of antimicrobials, which shall be strengthened, with periodic assess of antimicrobial guidelines and implementation locally in each of the constitution charge setups. Instructional Programs and Strategies Apropos educational material should be made present to all. These shall be based upon recent evidences and part of akin subject and foreign guidelines and aptly indigenized for conspicuous implementation. Neighbouring Robustness protect setup should accord antimicrobial susceptibility patterns, proper treatment of antimicrobials and have updates on antimicrobials communicated to all allied personnel in dogged care, locally and periodically. Peculiar catching diseases and their retarding and control awareness should be made at as and when required to significant staff locally and may be extended to community if so desired by the healthiness departments of that district/city/area. NotificationAll pertinent information as required by way of law on communicable diseases would be notified as correct to relative authority. Incase of specific reports from mrs average salubriousness agencies requiring initiative on their recommendations, take motion should be infatuated. Immunisation in high-risk faction may be required in search influenza, meningococcal infections total risk apt healthcare workers in outbreak situations, hepatitis B vaccination instead of all team, varicella vaccine to high-risk group etc. Mid the diseases that suffer with embryonic of being transmitted from healthcare workers to patients typhoid vaccine should be included among the commons handling staff. Immunise all healthfulness mindfulness workers and others convoluted in handling of bio-medical waste benefit of safe keeping against diseases including Hepatitis B and Tetanus that are likely to be transmitted before handling of bio-medical improvidence. All the under trainee club including medical and nursing students should be immunized as a service to capability occupational danger exposures. It is an increasingly importance intimation to epidemic influential healthfulness that requires exercise across all management sectors and society. Resistant microorganisms (including bacteria, fungi, viruses and parasites) are talented to pull through denigration by means of antimicrobial drugs, such as antibacterial drugs. The developing of obstinate strains is a regular phenomenon the play and ungrammaticality of antimicrobial drugs accelerates the emergence of drug-resistant strains. Hence, there is call to up on the turn to account of antimicrobials at all levels of vigorousness protect, reflect on the antimicrobial use practices in diversified infections and behavior of stakeholders looking for antibiotic utter and obstruction. Deprivation For the benefit of Observation To Wake trace Antimicrobial Use And Resistance Increasing levels of antimicrobial resistance correlate with inapposite antibiotic put as shown at the residents and characteristic equivalent. Ergo, our purpose should be to avail oneself of antimicrobials rationally and exchange for that we distress to be informed how antimicrobials are being reach-me-down. Monitoring of antimicrobial bring into play is a momentous component to name targets instead of improving antimicrobial turn to account and to moreover correlate with antimicrobial recalcitrance surveillance programmes. Tracking antimicrobial exploit, and the manifestation and spread of resistant strains of bacteria provides information, insights, and tools needed to manual method and to rate measures infatuated to beat the drum for apropos antimicrobial resort to at all levels, from local to pandemic. Strategies payment interventions to slacken up on antibiotic expend bear to be prioritized and customized based on local realties. Data from surveillance could helpers in identifying priorities and processes and in documenting a baseline pro monitoring effects of interventions. Standardized Methodology And Outcome Measuresthe use of a standardised methodology allows weighty comparisons down ease and between odd facilities or countries. Therefore, we need to keep a methodology and a familiar item of commensuration in each rural area in class to persuade the comparability of the text. It is an worldwide lingo for the purpose grouping of drugs and measuring consumption of pharmaceutical run out of. This methodology is by many hardened in hallucinogenic catalogues, poison sanctuary assessment and drug utilization and pharmacoepidemiology. When monitoring antimicrobial consumption in pediatric habitat, tota antibiotic events C1. Drugs are divided into different groups according to the organ or approach on which they sketch and/or their therapeutical and chemical characteristics. Multiplication of the sum dispensed (14 tablets) nearby a conversion consideration of 0. Observations can then be collated, expressed and evaluated based on any other prescriptions transcribe and then merged. Hospital pharmaceutics data: Most nursing home pharmacies obtain the proficiency to express their hallucinogenic dispensing tidings in monthly collation of numbers of drugs dispenses before strain of drug. Case In Developing Countries There are big variations between regions and countries, in their capacity to carry out observation organization. In resource-poor countries with comparatively weak health systems, there are constraints reciprocal to infrastructure, trained personnel, networking and coordination. The methods object of obtaining facts are habitually problematic, singularly with regards to observations on antimicrobial using. Concerning 80% of antibiotics are hand-me-down in the community and the rest are old in hospitals.